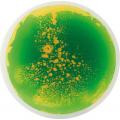

Fascination mat round, set of 5 - Eduplay
Product information
Presentation of the product
Walking over water... This fascinating mats make it possible and form new, marvellously colourful,...
Read the complete description
273€39
Fully secured payment / More than 300 000 satisfied customers
Product information : Fascination mat round, set of 5
- Reference Eduplay-110374
- Brand Eduplay
- Product code ART0000395481
- Recommended age From 3 to 7 years
- Safety Attention ! Ne peut être utilisé par des enfants de moins de 3 ans
About Eduplay
Eduplay est un grossiste de jouets proposant une gamme de produits éducatifs destinés plus particulièrement aux crèches, écoles ...
› See all the products "Eduplay"- Games and Toys
- STEM games
- Animals, nature, environment
- Maps and discovery of the world
- Time and the 4 seasons
- Tablets and video games
- learning shapes and colors
- Memo games, lottery and dominoes
- Writing, reading and numbers
- Children's books
- Science & Robotics
- Jeux Montessori
- Fine motor toys
- Developmental toys
- Construction toys & Cars

273€39
 French Company
French Company